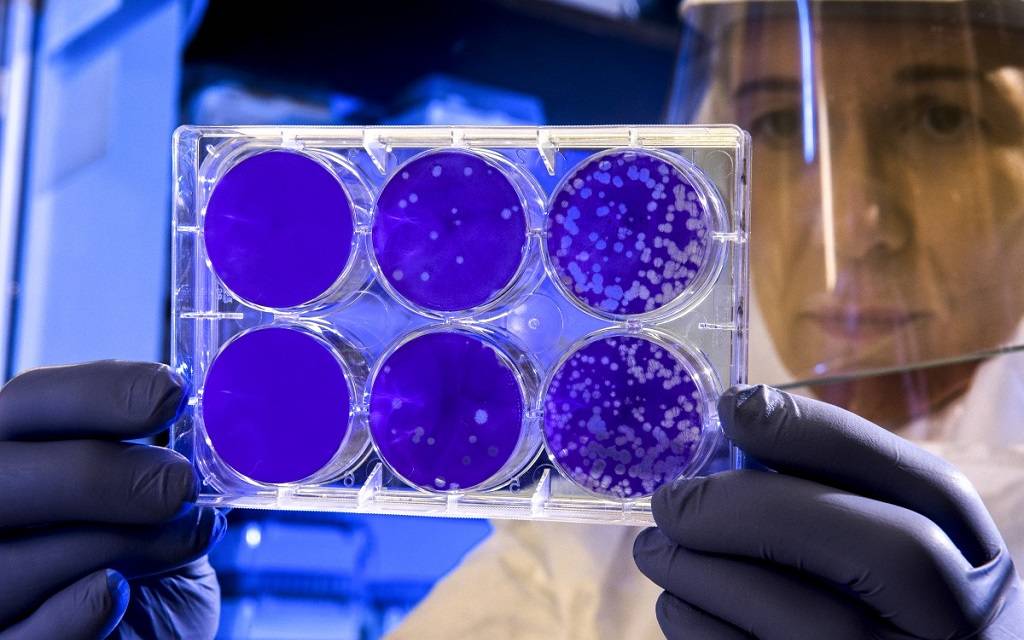

Corona-Mutation
Veröffentlicht: Mittwoch, 03.02.2021 11:55
Erster Hinweis auf südafrikanische Corona-Mutation im Kreis Steinfurt - Landrat mahnt zu Disziplin und Besonnenheit
Acht Menschen aus Rheine, Ibbenbüren und Ochtrup haben sich vermutlich mit mutierten Coronaviren angesteckt. Zum ersten Mal gibt es neben labortechnischen Hinweisen auf die auf britische Variante auch einen auf die südafrikanische Mutation. Sechs der Betroffenen gehören zu zwei Familien. Die Analyse der Tests ist aufwändig. Der Kreis Steinfurt erwartet die ersten Laborergebnisse in sieben bis zehn Tagen.
Landrat Sommer: "Das Erreichte nicht gefährden"
"Gestern waren wir froh, zum ersten Mal seit dem 24. Oktober eine Inzidenz von unter 50 zu haben", sagt Landrat Martin Sommer – und weiter: "Wie wichtig es dennoch ist, dass wir uns alle strikt an die Corona-Schutzregeln halten, wird jetzt nochmals deutlich. Bitte bleiben Sie geduldig und befolgen weiterhin die Corona-Schutzempfehlungen, um das Erreichte nicht zu gefährden. Die Inzidenz liegt heute übrigens schon wieder über 50, nämlich bei 55.


